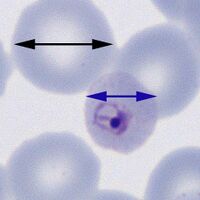

Red cell size
From haematologyetc.co.uk
Navigation
Go Back
| How is red cell size and shape affected as malaria develops?
SMALL ROUND RED CELLS P.malariae The red cells in this species remain round and are often small in size The early (A) and late trophozoites (B) shown in this image each lie within round erythrocytes with reduced size.
RED CELLS WITH UNCHANGED SIZE AND SHAPE P.falciparum (and P.knowlesi) Red cell size and shape is generally unchanged although they may become crenated
The early (A) trophozoites lie within red cells that do not change size or shape, at later development (B) they may remain unchanged or acquire subtle crenation.
ENLARGED AND DISTORTED RED CELLS For both P.ovale and P.vivax the red cells become progressively enlarged and distorted as the parasites develop. It may not be possible to distingish the species based on red cell appearances, but there are differences which should be looked for.
Expect increased red cell size but this may not be marked; the typical shape is an ovoid shape (hence the name) and there may be characteristic finbriation of cytoplams (that may be limited to one pole of the cell).
Early (A) and late (B) trophozoites o P.ovale. In each case there is a tendency for red cells to have an ovoid shape and there is distortion of the cytoplasm with sharp projectiosn (fimbriation). These orregular and spiky projections differ from the rounded crenation that may be seen in P.falciparum.
P.vivax This species tend to have the largest red cell size that becomes evident at quite and early stage; the typical shape is quite irregular fimbriation is not (generally) seen.
Early and trophozoites of P.vivax. The increased size and red cell distortion increase as the parasites mature. In this case the early trophozoite (A) is enlarged but still retains a relatively undistorted elongated shape (similar to P.ovale); however the late form (B) is has a very irregular shape (note there is no fimbriation).
|